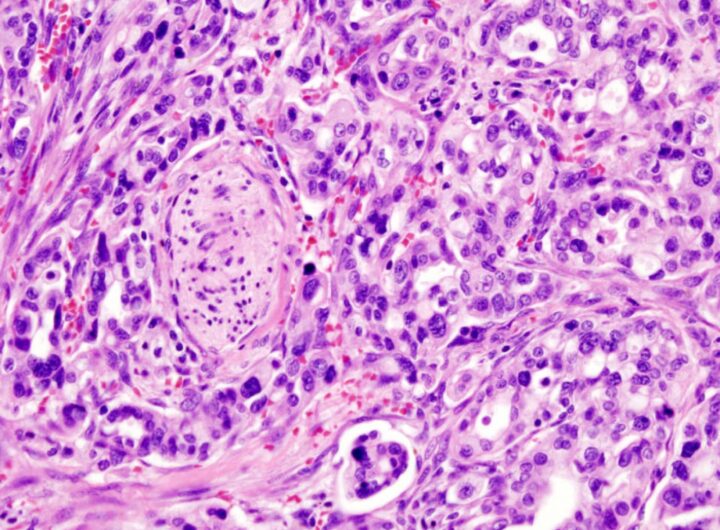

Il comune di Palermo: divieto di detenzione per chi ha ucciso Aron Il comune di Palermo: divieto...
Scienze naturali
Scienze Naturali su Perchè.eu
Introduzione
Perchè.eu è un blog dedicato all’esplorazione e all’apprezzamento delle scienze naturali. Attraverso una serie di articoli informativi e stimolanti, il blog si impegna a rispondere a tutte le tue domande sul mondo naturale.
Il blog si distingue per la sua capacità di spiegare concetti scientifici complessi in un linguaggio semplice e comprensibile. “Perchè” non è solo un titolo, ma una filosofia guida, un invito a chiedere e a cercare risposte.
Scopri il mondo della Scienze Naturali
La categoria delle Scienze Naturali su Perchè.eu copre un’ampia gamma di argomenti, che spaziano dalla biologia alla geologia, dalla botanica all’astronomia. Ciò la rende una risorsa preziosa per chiunque sia interessato a imparare di più sul nostro mondo naturale.
Uno dei punti di forza di questo blog è la qualità dei suoi articoli. Ogni post è curato nei minimi dettagli, con uno stile di scrittura coinvolgente e accessibile. Puoi trovare risposte alle domande più curiose, come Perchè il cielo è blu? o approfondimenti su fenomeni naturali, come i terremoti o la vita delle piante.
Approfondimenti e risorse utili
In aggiunta ai contenuti del blog, Perchè.eu offre anche una serie di link esterni che possono arricchire ulteriormente la tua comprensione delle scienze naturali. Tra questi, siti come il Museo di Storia Naturale di Milano o il Planetario di Roma, che offrono una moltitudine di risorse educative e di approfondimento.
Inoltre, per chi desidera una comprensione più tecnica, sono disponibili link a risorse scientifiche riconosciute a livello internazionale, come Nature Italia, che offre accesso a una vasta gamma di articoli scientifici e di ricerca.
Conclusione
Perchè.eu è una risorsa indispensabile per chiunque abbia un interesse nelle scienze naturali. Il suo approccio semplice, ma approfondito, combinato con una vasta gamma di argomenti, lo rende un luogo ideale per scoprire e imparare.
Il blog risponde non solo alla domanda “Cosa?”, ma anche a “Perché?”. E’ un luogo di scoperta, di apprendimento, ma soprattutto di meraviglia verso il mondo naturale che ci circonda. Un luogo in cui potrai sempre chiedere “Perché?” e trovare una risposta.